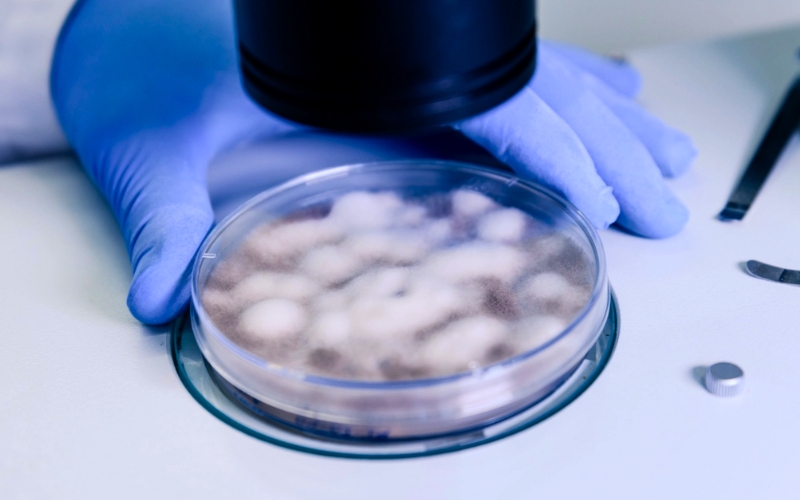

Courses under Aashakiran Fertility Academy
Courses under Andrology
Courses under Embryology
Courses under Hands-on Training
Courses under Fellowship Program
Courses Offered by Aashakiran Fertility Academy

Certificate Course in Clinical Embryology

Certificate Course in Reproductive Medicine
Why Choose Aashakiran Fertility Academy?
Expert Faculty
Learn from renowned embryologists and fertility experts with years of hands-on experience and a deep understanding of advanced reproductive technologies.
State of the Art Labs
Train in cutting-edge embryology laboratories equipped with the latest tools and technologies used in real-world IVF practices.
Comprehensive Curriculum
Our courses cover every aspect of clinical embryology, including IVF, ICSI, cryopreservation, and quality control, ensuring a thorough understanding of the field.
Hands-On Training
Gain practical, hands-on experience with live case studies and advanced techniques, preparing you for real-world challenges in embryology.
Recognized Certification
Receive an industry-recognized certificate upon course completion, enhancing your credentials and career prospects in the field of reproductive medicine.
Personalized Learning
Small batch sizes ensure personalized attention and one-on-one mentorship, allowing for a tailored and enriching learning experience.
Proven Excellence
As the fastest-growing IVF chain in Punjab, Aashakiran IVF brings unparalleled expertise and a reputation for excellence to its training programs.
Networking Opportunities
Join a growing community of professionals, gaining access to a network of specialists and potential career opportunities.
Advantages of Choosing Aashakiran Fertility Academy
- Expert Faculty
- Advanced Labs
- Comprehensive Curriculum
- Hands-On Training
- Recognized Certification
- Personalized Mentorship
- Industry Expertise
- Career Opportunities
- Quality Assurance
- Innovative Techniques
- Flexible Learning
- Proven Excellence

Frequently Asked Questions About AFA
AFA is a premier training institute dedicated to educating and training future embryologists and fertility specialists through comprehensive courses in clinical embryology and assisted reproductive technology (ART).
The course is designed for life science graduates, medical professionals and aspiring embryologists who want to specialize in IVF, ICSI, cryopreservation and embryo culture techniques.
We offer two flexible course durations: a 6-month intensive program and a 1-year comprehensive training program.
Our structured syllabus includes lab setup, quality control, semen analysis, oocyte handling, embryo grading, freezing, ICSI training and hands-on practical experience.
Yes, AFA provides extensive hands-on training using real lab equipment and techniques, ensuring practical expertise in embryology and ART procedures.
AFA combines expert-led theoretical knowledge, hands-on practical experience and cutting-edge technologies like Virtual Reality (VR) simulations to offer the most advanced training in fertility sciences.
Yes, upon successful completion of the course, students receive a certification in Clinical Embryology, which is recognized in the fertility industry.
Graduates can pursue careers as embryologists, IVF lab specialists and ART consultants in leading fertility clinics and research institutions worldwide.
You can apply by visiting our website, filling out the application form, or contacting us at 872-8081-222 for more details.
AFA training will be held at the Aashakiran center in Kharar, offering top-tier facilities and expert-led instruction.
Our Blogs
PRP Therapy in IVF: A New Hope in Fertility Treatment
2026-05-28T08:50:04+00:00By AashakiranIVF|Female Infertility, Fertility Treatment, Male Infertility, Pregnancy|
Our Updates
Aashakiran IVF Expands to Haryana: MOU Signed with Amaanat IVF & Fertility
2026-03-21T11:05:00+00:00By AashakiranIVF|Updates|





Our Centers
Kharar, Mohali , Punjab
Aashakiran IVF Private Limited
Sector-127, Gillco Valley
Kharar, Mohali, Punjab 140301
Ludhiana, Punjab
Aashakiran IVF Private Limited
Street No-4, Ranjit Nagar, Opp. GLADA Office, Ferozepur Rd, Ludhiana, Punjab 141012
Amritsar, Punjab
Aashakiran IVF Private Limited
SCO-44, 4th Floor, 97 Acre Project
D-Block, Ranjit Avenue
Amritsar, Punjab 143001
Bathinda, Punjab
Aashakiran IVF Private Limited
SCO-8, PUDA Complex
100 ft Road, Bathinda
Punjab 151001
Ambala, Haryana
Aashakiran IVF Private Limited
15 Medha Tower, Navneet Nagar,
Near Kalka Chowk, Grand Trunk Rd.
Ambala, Haryana 134003
Corporate Office
Aashakiran IVF Private Limited
SCO-33, Sector-127, Gillco Valley
Kharar, Mohali, Punjab 140301
ART Bank
Aashakiran ART Bank
SCO-33, Sector-127, Gillco Valley
Kharar, Mohali, Punjab 140301